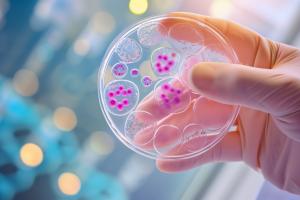
Est-ce le secret du maintien d'un système immunitaire jeune ? (Visuel Adobe Stock 734718208) Est-ce le secret du maintien d'un système immunitaire jeune ? (Visuel Adobe Stock 734718208)

Vous recherchez une actualité ou un dossier
Recherche (liste)
Mode d'affichage :
-
SYSTÈME IMMUNITAIRE : L’impact indiscutable du régime alimentaire
Actualité publiée le 09/01/2025SYSTÈME IMMUNITAIRE : Comment le préserver chez le patient âgé ?
Actualité publiée le 29/11/2024
-
SYSTÈME IMMUNITAIRE : La souris TruHuX qui en a les atouts
Actualité publiée le 23/09/2024SYSTÈME IMMUNITAIRE : Des cellules T qui squattent les tissus durant des années
Actualité publiée le 03/06/2022
-
MICROBIOME INTESTINAL : Comment il se connecte à notre système immunitaire
Actualité publiée le 14/11/2021SYSTÈME IMMUNITAIRE : Trop de sel pourrait le "sucrer"
Actualité publiée le 08/05/2021
-
SYSTÈME IMMUNITAIRE : Les secrets de son bon fonctionnement
Actualité publiée le 08/04/2021SYSTÈME IMMUNITAIRE : Son autre mission, combattre la dépression ?
Actualité publiée le 24/09/2020
-
SYSTÈME IMMUNITAIRE : L’approche périscope pour une vision de l’immunité
Actualité publiée le 04/08/2019CANCER du FOIE : L’espoir d’une immunothérapie radicale
Actualité publiée le 12/06/2019